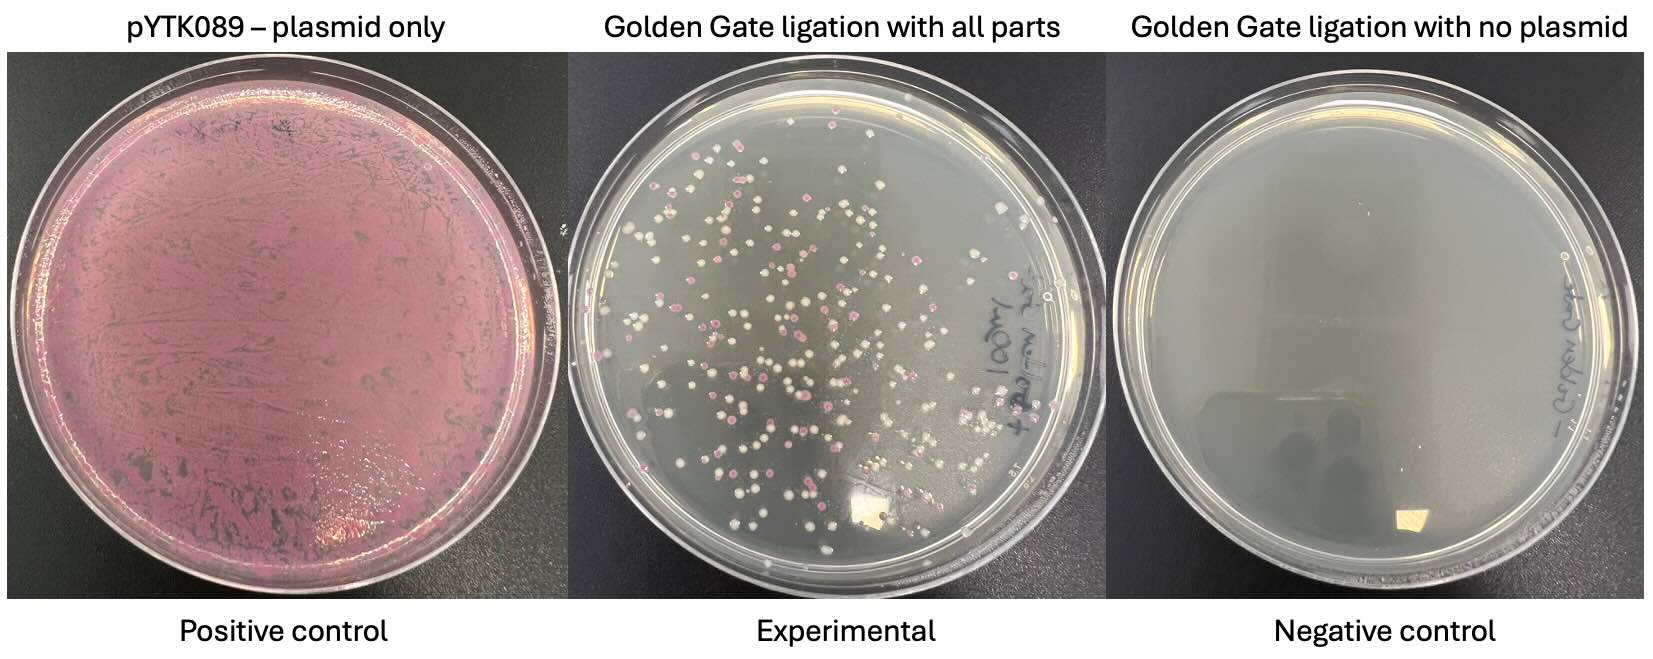
Bacterial transformation results

Hosting Nuffield students
August 04, 2025
This year we hosted three Nuffield students for a two week research placement.
Angela and Anna hosted three young people through the Nuffield placements to learn and experience science first hand. In this project, the students learned about and performed PCRs, Golden Gate ligations, E. coli transformations, plasmid extractions, and restriction enzyme digests. They were also supported while writing a report describing their experiments and a poster to be shared with their peers.
For more information about training opportunities see Earlham Institute Training.
